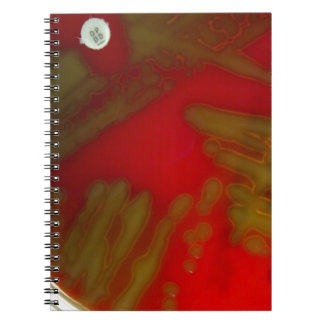
Penumonia Bacteria Notebook

About
We specialize in scientific organisms, microscopic microorganisms, and difficult to find sayings and images.
Products
View All ProductsPenumonia Bacteria Metal Ornament
Price$46.55
Blood Parasite Trypanosoma Key Ring
Price$10.75
MRSA T-Shirt
Price$34.50
Staph Love Me in white iPhone 11 Case
Price$78.10
Staph love me T-Shirt
Price$35.30
Heart worm T-Shirt
Price$34.50
Aquarium Fish Photo Postcard
Price$2.75
Hand Petri Dish Bacteria Coffee Mug
Price$23.45
Get Your To Class T-Shirt
Price$34.50
3D Yeast microscopic wet mount Coaster
Price$52.70
Parasite Trichinella spiralis Tie
Price$44.85
Blood Parasite Trypanosoma Tie
Price$44.85
Staph Love Me red Tie
Price$44.85
3D Yeast microscopic wet mount Coaster
Price$19.45
Penumonia Bacteria Notebook
Price$21.65
Recently Viewed Items